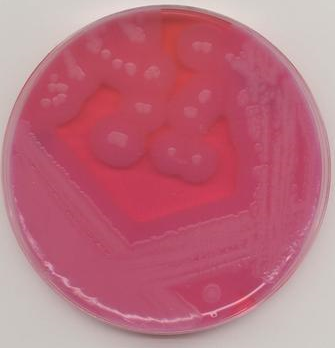
植物血球凝集素

植物血球凝集素
的有关信息介绍如下:
植物血球凝集素(PHA) phytohaemagg lutinin 对原来从植物中发现的,具有凝集红血球作用的物质,而命名的,后来发现了很多具有同样作用的物质,扩大其含义为细胞凝集素中植物来源的总称——植物凝集素(phytoagglutinin,plant agglutinin)或凝集素(lectin)。
想要了解更多“植物血球凝集素”的信息,请点击:植物血球凝集素百科
植物血球凝集素(PHA) phytohaemagg lutinin 对原来从植物中发现的,具有凝集红血球作用的物质,而命名的,后来发现了很多具有同样作用的物质,扩大其含义为细胞凝集素中植物来源的总称——植物凝集素(phytoagglutinin,plant agglutinin)或凝集素(lectin)。
想要了解更多“植物血球凝集素”的信息,请点击:植物血球凝集素百科